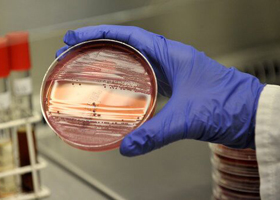
Диагностика кишечной палочки Диагностика кишечной палочки

Кишечная палочка (Escherichia coli) — один из основных представителей нормальной микрофлоры кишечника человека, играющий важную роль в поддержании здоровья. Некоторые штаммы этой бактерии могут вызывать серьезные заболевания, в то время как другие способствуют пищеварению и синтезу витаминов. Понимание симптомов и методов лечения инфекций, вызванных патогенными штаммами кишечной палочки, важно для взрослых и детей, так как это помогает своевременно распознать проблему и принять меры. В статье рассмотрим основные аспекты кишечной палочки, ее влияние на здоровье и подходы к лечению, что поможет читателям лучше ориентироваться в теме и заботиться о своем благополучии.
Патогенез
Эшерихии проникают в организм через рот и проходят через желудок в кишечник, где, обладая инвазивными и цитотоксическими свойствами, колонизируют слизистую оболочку тонкого кишечника. Это приводит к повреждению цитоплазмы клеток, отслоению эпителиоцитов и образованию эрозий с умеренным воспалением. Размножение энтеропатогенных кишечных палочек (ЭПКП) происходит на поверхности энтероцитов, и при их проникновении в клетки происходит их разрушение. В патогенезе эшерихиозов ключевым фактором является нарушение структуры клеточных мембран энтероцитов и лимфоцитов, а также ускорение окислительных процессов липидов.
Энтеротоксигенные E. coli вырабатывают несколько видов токсинов:
- Термостабильный токсин — повышает уровень циклического гуанозинмонофосфата (цГМФ) внутри клеток, что подавляет всасывание ионов Na и Cl эпителиальными клетками. Рецепторы для этого токсина в основном находятся на энтероцитах тонкой кишки.
- Термолабильный токсин (на 80% схож со структурой холерного токсина) воздействует через циклический аденозинмонофосфат (цАМФ), который при повышении концентрации стимулирует выделение ионов Cl.
- Цитотоксические факторы, вызывающие наркотизацию, способствуют реорганизации цитоскелета, что приводит к образованию складок на мембране и замедляет деление клеток слизистой оболочки. Сглаживание ворсинок эпителия способствует адгезии бактерий и увеличивает их рост в просвете кишечника.
- Цитолетальный расширяющий токсин блокирует процесс деления клеток, в результате чего они становятся многоядерными и погибают через несколько дней.
Выделяемые термолабильный и термостабильный энтеротоксины активируют аденилатциклазу клеточных мембран, что приводит к значительному увеличению уровня цАМФ в энтероцитах и повышению секреции воды и электролитов в просвете кишечника. Нарушения внутриполостного и мембранного пищеварения, а также снижение обратного всасывания жидкости приводят к развитию секреторной диареи (диарейного синдрома) с нарушением водно-электролитного баланса. При выраженном диарейном синдроме, сопровождаемом рвотой, может возникнуть обезвоживание, что приводит к токсикозу с эксикозом. Уменьшение объема циркулирующей крови вызывает метаболический ацидоз и нарушения аминокислотного баланса, что в конечном итоге приводит к потере массы тела.
- Механизм патогенности энтероинвазивных кишечных палочек (ЭИКП). Патогенез ЭИКП схож с шигеллезом, однако воспалительные изменения в кишечнике и токсикоз при эшерихиозах выражены менее значительно. Основой патогенеза инфекции, вызванной ЭИКП, является способность кишечной палочки внедряться и размножаться в клетках эпителия слизистой оболочки кишечника, вызывая ее разрушение. Поскольку синтез мембранных белков, участвующих в инвазии, кодируется, ЭИКП не могут производить термостабильные и термолабильные токсины, поэтому их патогенность ограничивается инвазивностью и развитием воспалительной реакции с образованием язв.
- Механизм патогенности энтеропатогенных кишечных палочек (ЭПКП). При попадании в просвет кишечника ЭПКП размножаются и колонизируют, вызывая отслоение микроворсинок энтероцитов тонкой кишки и способствуя развитию воспалительного процесса с симптомами мальабсорбции/ мальдигестии и процессов брожения. Развивается отек слизистого и подслизистого слоев, умеренная гиперемия, геморрагии, дистрофические изменения в энтероцитах, гиперплазия фолликулярного аппарата с некрозом и поверхностными язвами. Токсины, вырабатываемые ЭПКП, и побочные продукты нарушенного пищеварения становятся причиной интоксикации.
- Механизм патогенности энтерогеморрагических кишечных палочек (ЭГКП). Этот штамм (серогруппа О157/серовар О157:Н7) часто называют «гемолитической кишечной палочкой». Такое название связано с его способностью разрушать клетки эндотелия мелких кровеносных сосудов, что приводит к гемолизу и, как следствие, гемолитической анемии. Гемолитическая E. coli может вызывать гемолитико-уремический синдром (ГУС), который часто заканчивается летальным исходом. Гемолизирующая эшерихия активно вырабатывает эндотоксины, которые являются основным патогенным фактором; один из них антигенно и структурно схож с токсином Шига, а другой — с дизентерийным токсином. Наиболее чувствительными к этим токсинам являются клетки сосудистого эндотелия. Гемолитико-уремический синдром проявляется признаками гемолитической анемии, тромбоцитопенией, поражением почек и нестабильными нарушениями функций ЦНС. Полиорганная патология при ГУС обусловлена повышенным поступлением бактериальных липополисахаридов в системный кровоток, вызванным нарушением барьерной функции кишечника из-за повреждающего действия возбудителя и его токсинов. Учитывая серьезность клинического течения эшерихиозов, вызванных ЭГКП, крайне важно контролировать наличие гемолитических E. coli в кале как у детей, так и у взрослых, особенно у грудничков.
- Механизм патогенности энтероагрегативных кишечных палочек (ЭАКП). Эти бактерии колонизируют эпителий тонкой кишки и прочно прикрепляются к его поверхности. На данный момент факторы патогенности этих возбудителей изучены недостаточно.
При эшерихиозах морфологические изменения в основном наблюдаются в тонком кишечнике и проявляются:
- умеренной отечностью и гиперемией слизистого и подслизистого слоев;
- геморрагиями;
- изменениями структуры энтероцитов и дистрофическими изменениями в них;
- гиперплазией фолликулярного аппарата с некрозом и поверхностными язвами;
- образованием воздушных полостей ( пневматоз) в подслизистом слое.
https://youtube.com/watch?v=TvF-hO9wiwU
Классификация
Существует множество серотипов кишечной палочки, включая патогенные (энтеровирулентные), которые могут вызывать различные клинические проявления эшерихиозов. Эти серотипы объединены в несколько групп и типов, основным критерием для которых являются антигенные различия (антигенный комплекс). Выделяются следующие категории:
- соматические термолабильные К-антигены – 85 серотипов;
- соматические термостабильные О-антигены – 175 серотипов;
- жгутиковые термолабильные Н-антигены – 55 серотипов.
С точки зрения этиологии патогенные (диарейные) кишечные палочки делятся на несколько групп:
- Энтероинвазивные. Эти бактерии способны проникать в слизистую оболочку кишечника и размножаться в ней. Энтеропатогенная кишечная палочка выделяет эндотоксин и вызывает заболевания, схожие с острыми кишечными инфекциями, вызываемыми шигеллой, с клинической картиной, напоминающей шигеллез у взрослых и детей старше одного года. К распространенным штаммам относятся E. coli О124, E. coli О154 (Крым), О129, О144, О151, О164.
- Энтеропатогенные. Эти бактерии вызывают кишечные заболевания у детей младше одного года и диарею у путешественников среди детей старше года и взрослых. Они имеют антигенное сходство с сальмонеллами. Энтеропатогенные штаммы размножаются на слизистой тонкого кишечника, проникая в него и вызывая очаговое воспаление. Они производят два типа токсинов: нейротропный термолабильный экзотоксин и энтеротропный термостабильный эндотоксин. К ним относятся штаммы E. coli: О26, О44, О86, О114, О119, О125, О127, О142, О158. Энтеропатогенные эшерихии классифицируются на два класса в зависимости от их взаимодействия с клеточными культурами.
- Энтеротоксигенные. Эти бактерии колонизируют нижнюю часть тонкого кишечника и производят термолабильные и термостабильные энтеротоксины, а также экзотоксин, схожий с холерогеном. Энтеропатогенная флора способствует выделению жидкости в просвет тонкого кишечника, что приводит к холероподобным заболеваниям. Штаммы E. coli: О1, О6, О15, О25, О78, О148, О159.
- Энтерогеморрагические. Эти бактерии производят цитотоксины, родственные шигатоксину, и являются возбудителями заболеваний, схожих с дизентерией, протекающей с геморрагическим колитом. Изолированная ЭГКП имеет код О157:Н7.
- Энтероаггрегативные. Для этой группы характерно легкое, но продолжительное течение болезни. Чаще всего страдают дети и взрослые с ослабленным иммунитетом.
В зависимости от клинических проявлений эшерихиозы классифицируются на:
- гастроэнтеритические;
- энтероколитические;
- гастроэнтероколитические;
- генерализованную форму ( коли-сепсис, холецистит, менингит, пиелонефрит).
По степени тяжести заболевания выделяют:
- легкую;
- средней тяжести;
- тяжелую.
Кишечная палочка, или Escherichia coli, вызывает множество обсуждений среди людей. С одной стороны, это обычный обитатель кишечника человека и многих животных, играющий важную роль в пищеварении и поддержании микрофлоры. Однако, некоторые штаммы этой бактерии могут быть опасными и вызывать серьезные заболевания, такие как гастроэнтерит и инфекции мочевыводящих путей. В результате, многие люди относятся к кишечной палочке с настороженностью, особенно после случаев вспышек инфекций, связанных с contaminated food или водой. В то же время, в научных кругах кишечная палочка активно изучается и используется в биотехнологиях, например, для производства инсулина. Таким образом, мнения о ней варьируются от полезной до опасной, что делает ее объектом интереса как для медиков, так и для широкой общественности.
| Аспект | Описание | Значение для человека |
|---|---|---|
| Виды | Комменсальные (непатогенные): Обитают в норме в кишечнике, участвуют в синтезе витаминов (К, группы В), расщеплении пищи. Патогенные: Вызывают заболевания. |
Положительное: Поддержание здоровья кишечника, синтез витаминов. Отрицательное: Развитие инфекций, отравлений. |
| Пути передачи | Фекально-оральный: Через загрязненную воду, пищу, немытые руки, контакт с инфицированными животными. | Высокий риск заражения: Несоблюдение гигиены, употребление некачественных продуктов. |
| Симптомы инфекции | Диарея (водянистая, с кровью), рвота, боли в животе, лихорадка, обезвоживание. В тяжелых случаях — гемолитико-уремический синдром (ГУС). | Разнообразные: От легкого недомогания до угрожающих жизни состояний. |
| Профилактика | Тщательное мытье рук, термическая обработка пищи, употребление чистой воды, избегание контакта с больными животными, правильное хранение продуктов. | Ключевое значение: Предотвращение заражения и распространения инфекции. |
| Лечение | В основном симптоматическое (регидратация), в некоторых случаях — антибиотики (по назначению врача). | Важно: Своевременное обращение к врачу, предотвращение осложнений. |
Причины развития и факторы, способствующие заболеванию
https://youtube.com/watch?v=-PwNDt0-37A
Этиология
К возбудителям кишечных эшерихиозов относятся диарейные кишечные палочки (Diarrheagenic E. coli) из семейства Enterobacteriaceae, рода Escherichia (E. coli), обладающие множеством антигенных вариантов. Серовары как патогенных, так и непатогенных E. coli не имеют морфологических различий. На следующем изображении представлена кишечная палочка.
Микробиология: кишечная палочка — это утолщенные грамотрицательные бактерии, размеры которых колеблются от 3,0 до 1,5×0,3-0,8 мкм; они имеют жгутики, не образуют спор и отличаются изменчивостью в отношении подвижности. Эти бактерии активно ферментируют простые углеводы и выделяют специфические бактерицидные вещества.
Кишечные палочки обладают высокой устойчивостью в окружающей среде и могут размножаться в различных продуктах питания. Они способны сохраняться в испражнениях, на предметах обихода, в воде и почве в течение длительного времени — от 1 до 3 месяцев. При какой температуре они погибают? В кипятке — мгновенно; при 60 °С — через 15 минут. Бактерии чувствительны к 1-3% растворам хлорамина, хлорной извести, фенола и лизола, которые инактивируют их в течение 30 минут. У многих штаммов наблюдается высокая резистентность к различным антибиотикам.
Эпидемиология
Диарейные заболевания, как у взрослых, так и у детей, являются распространенной проблемой по всему миру, с оценками Всемирной организации здравоохранения, указывающими на до 280 миллионов случаев в год. В числе возбудителей острых кишечных инфекций (ОКИ) значительное место занимает E. coli: среди взрослых этот показатель колеблется от 5 до 15%, а у детей младше трех лет достигает 29,5-81,8%. Эшерихиозы составляют около 3% от общего числа зарегистрированных ОКИ, а среди малышей раннего возраста они занимают лидирующие позиции среди диарейных заболеваний. Основным источником инфекции являются больные люди, чаще всего с бессимптомными формами эшерихиоза, в меньшей степени — носители и выздоровевшие. Риск передачи инфекции значительно возрастает, если носители участвуют в приготовлении пищи или продаже продуктов.
Согласно имеющимся данным, основным источником серовара О157 (энтерогеморрагический эшерихиоз) является крупный рогатый скот. Заражение людей происходит через употребление недостаточно термически обработанных мясных продуктов, что подтверждается вспышками эшерихиоза в США, Японии и Канаде. Контаминация мяса может происходить как в процессе выращивания скота, так и после убоя животных.
Наибольшую эпидемическую опасность представляют больные эшерихиозами и носители кишечных палочек ЭПКП и ЭИКП, которые выделяют возбудителя в окружающую среду в течение 1-3 недель. Больные, страдающие от эшерихиозов, вызванных ЭТКП и ЭГКП, являются контагиозными только в первые 3-4 дня. При этом для энтеропатогенных сероваров характерна зимне-весенняя сезонность, а для энтероинвазивных и энтеротоксигенных — летне-осенняя. Люди обладают высокой восприимчивостью к диарейным эшерихиям, особенно среди ослабленных и новорожденных детей. Следует отметить, что около 30% детей, контактирующих с источником инфекции, становятся носителями.
Передача инфекции происходит фекально-оральным путем, чаще всего через пищу. Наибольшую опасность представляют молочные и готовые мясные продукты, немытые овощи и напитки (например, компот и квас), которые являются основными факторами передачи возбудителя. Реже встречается водный путь передачи эшерихиозов. Загрязнение открытых водоемов (рек, морей, озер) также представляет опасность. Основные причины попадания кишечной палочки в водоемы — сброс необезвреженных сточных вод, включая фекальные.
Например, анализ проб воды на черноморском побережье Крыма (пляжи Лазаревского, Феодосии, Алушты, Гурзуфа, Коктебеля, Партенита), а также на пляжах Краснодарского края (в Анапе, Сочи, Геленджике) и в Абхазии в 2017-2018 годах неоднократно показывал превышение норм по индексу лактозопозитивных кишечных палочек, что указывает на высокую степень микробного загрязнения. Это свидетельствует о том, что в черном море в разгар курортного сезона уровень кишечной палочки часто превышает допустимые нормы, и такие пляжи должны закрываться для купания. Аналогичные данные о загрязнении воды были получены в Болгарии, Турции и других балканских странах. Купание в такой воде не рекомендуется, так как существует риск заражения кишечной палочкой при случайном заглатывании воды. Поэтому многие туристы в Турции предпочитают плавать в бассейнах с морской водой, которые регулярно дезинфицируются.
Инфекция также может передаваться бытовым путем через предметы обихода (игрушки, посуду, руки персонала или матерей), что особенно актуально для детских коллективов.
При эшерихиозах, вызванных:
- ЭПКП — основной путь передачи у детей раннего возраста — контактно-бытовой, тогда как у взрослых и детей старшего возраста — через пищу.
- ЭИКП/ЭТКП — главный путь передачи — пищевой (через молочные продукты), менее значимый — водный.
Схематически механизм и факторы передачи возбудителя выглядят следующим образом:
https://youtube.com/watch?v=muycoXdYOp4
Особенности эпидемиологического процесса у различных групп кишечной палочки
Заболевания, вызванные эшерихиями серовара О157, могут проявляться как в виде единичных случаев, так и в форме эпидемических вспышек. Гемолитическая кишечная палочка у взрослых приводит к тяжелым формам эшерихиоза, и зафиксированы случаи смертельных исходов. В настоящее время гемолизирующая кишечная палочка считается одной из основных причин развития гемолитико-уремического синдрома (ГУС) и инфекционного гемоколита.
Эшерихиозы, вызванные ЭИКП, могут проявляться как спорадически, так и в виде групповых вспышек. Эти заболевания фиксируются во всех климатических зонах, имеют низкую контагиозность, чаще всего встречаются у детей в возрасте от 1,5 до 3 лет, имеют групповой характер и выраженную сезонность, особенно в летне-осенний период. Часто они проявляются как внутрибольничные инфекции. Эпидемические вспышки, связанные с пищей, характеризуются острым течением и быстро заканчиваются.
ЭПКП в основном приводят к спорадическим случаям заболеваний среди детей до 1 года, особенно тех, кто находится на искусственном вскармливании. Эти инфекции также регистрируются во всех климатических зонах и могут распространяться как внутрибольничные инфекции.
Эшерихиозы, вызванные ЭТКП, чаще всего встречаются в странах с влажным и жарким климатом, проявляются в основном в виде единичных случаев, реже — в виде эпидемий. Заболевают преимущественно дети в возрасте от 1 до 3 лет.
С современных позиций все клоны E. coli классифицируются по двум основным признакам: медицинскому (принадлежность к определенной категории патогенов человека) и экологическому.
| Подход (группирующий признак) | 1 группа | 2 группа | 3 группа | 4 группа |
| Экологический (принадлежность к конкретной категории симбионтов человека) | Мутуалисты | Комменсалы | Паразиты | «Случайные» симбионты («квартиранты» или «случайные» паразиты) |
| Медицинский (принадлежность к конкретной категории патогенов человека) | Непатогены (индигены) | Потенциальные патогены (возбудители ВКЭ) | Истинные патогены (возбудители ОКИ) | Непатогены (факультанты) или «случайные» патогены |
Такой подход позволяет выделить четыре группы (кластера) клонов кишечной палочки, что помогает понять механизмы формирования ОКИ эшерихиозной этиологии и внекишечных заболеваний, вызванных кишечной палочкой. Наибольшее значение имеют две группы, включающие патогенные эшерихии, ассоциированные с ОКИ, и потенциально патогенные кишечные палочки, являющиеся возбудителями внекишечного эшерихиоза (ВКЭ). Эти группы включают эшерихии, обладающие уникальными антигенными признаками и разнообразным составом.
Группа патогенных эшерихий включает в себя энтеропатогенные, энтероинвазивные, энтеротоксигенные, энтерогеморрагические и энтероагрегативные виды кишечных палочек. Несмотря на то, что все эшерихии этой группы вызывают диарею, они представляют собой различные варианты ОКИ, отличающиеся по эпидемиологическому процессу, патогенезу и клиническим проявлениям. Эти различия обусловлены наличием у возбудителей специфических факторов патогенности, которые определяют характер взаимодействия кишечной палочки с организмом человека.
В группе потенциально патогенных эшерихий также присутствуют различные подгруппы вариантов кишечной палочки, способствующие развитию различных нозологических форм ВКЭ, таких как дисбактериоз, пиелонефрит, цистит, холецистит, сепсис, менингит и гинекологическая патология.
К факторам, способствующим высокой заболеваемости эшериозом у детей первого года жизни, относится высокая восприимчивость, обусловленная:
- Анатомо-физиологическими особенностями системы ЖКТ (низкая бактерицидность и активность ферментов желудка и поджелудочной железы, повышенная проницаемость слизистой кишечника).
- Факторами, предрасполагающими к инфицированию, являются гипотрофия, рахит, анемия, дисбактериоз кишечника, искусственное питание или ранний переход на смешанное вскармливание.
Иммунитет
После перенесенного эшерихиоза формируется временный, специфичный для типа иммунитет, что означает, что защита вырабатывается только против определенного серовара эшерихий. Поскольку антитела к эшерихиям принадлежат к классу IgM, этот иммунитет оказывается недолговечным и сохраняется лишь на протяжении нескольких месяцев.
Внекишечные эшерихиозы (ВКЭ)
Возбудители ВКЭ представляют собой относительно изолированную группу эшерихий, обладающих схожими характеристиками, патогенный потенциал которых определяется совокупностью специфических биохимических, морфологических и генетических особенностей (особенностями биопрофилей). В большинстве случаев ВКЭ классифицируются как эндогенные инфекции, что означает, что они возникают в результате активации патогенного микроорганизма, уже присутствующего в организме, при этом основным резервуаром возбудителей служит кишечник человека. В процессе развития данной патологии, помимо роли E. coli, значительное внимание уделяется факторам риска, которые способствуют их возникновению.
Эти факторы создают условия для проникновения эшерихий во внутреннюю среду организма и обеспечивают благоприятные условия для их паразитирования в органах и тканях.
В таблице ниже представлена классификация факторов риска, способствующих развитию ВКЭ, а также результаты их воздействия:
| Этап патогенеза ВКЭ | Результат воздействия факторов риска | Группы факторов риска развития ВКЭ | |
| Эндогенные | Экзогенные | ||
| Вегетирование E. coli в кишечнике человека (преморбидный этап) | Уменьшение колонизационной резистентности и возникновение эндогенного источника возбудителей ВКЭ | * Дисбиоз (дисбактериоз) кишечника. * Острые и хронические заболевания (включая ОКИ, ОРВИ, болезни печени, пищеварительного тракта). * Новорожденные, недоношенные дети. * Иммунодефицитные состояния. | * Контакт с потенциально патогенными E. coli (в том числе внутрибольничными). * Искусственное вскармливание. * Антибиотико- и химиотерапия. |
| Миграция E. coli из кишечника во внутреннюю среду организма (этап транслокации) | Ускорение процесса транслокации E. coli, развитие бактериемии и инфицирование внутренних органов и тканей | * Дисбиоз (дисбактериоз) кишечника. * Острые и хронические заболевания (включая ОКИ, ОРВИ, болезни печени, пищеварительного тракта). * Иммунодефицитные состояния (включая лейкозы и эндокринопатии). | * Стрессовые факторы (включая травмы, операции). * Антибиотико- и химиотерапия. * Экополлютанты с иммунодепрессивным эффектом. |
| Фиксация E. coli во внутренних органах организма (этап колонизации) | Упрощение фиксации E. coli в тканях внутренних органов | * Наличие в тканях рецепторов для E. coli. * Иммунодефицитные состояния. * Нарушения морфофункционального статуса отдельных органов. | * Стрессовые факторы. * Тератогенные воздействия во время беременности. |
| Инициация воспалительного процесса во внутренних органах организма (этап альтерации) | Усугубление воспалительного процесса во внутренних органах | * Нарушения морфофункционального статуса отдельных органов. * Иммунодефицитные состояния (включая пожилой возраст, беременность). | * Стрессовые факторы. * Экополлютанты с иммунодепрессивным эффектом. |
| Элиминация E. coli из внутренних органов организма (этап санации) или выживание E. coli в них (этап персистенции) | Уменьшение эффективности механизмов саногенеза и создание условий для персистенции E. coli во внутренних органах | * Нарушения морфофункционального статуса отдельных органов. * Нарушения гемодинамики во внутренних органах (включая последствия склероза). * Иммунодефицитные состояния. | * Антибиотико- и химиотерапия. * Экополлютанты с иммунодепрессивным эффектом. |
Симптомы
Клинические симптомы эшерихиозов могут значительно варьироваться и зависят от типа патогена, состояния иммунной системы и возраста пациента. Существует несколько форм эшерихиоза, которые обусловлены различными видами возбудителей.
Клиника эшерихиоза, вызываемый сероварами энтеропатогенных кишечных палочек 1 и 2 класса (ЭПКП)
Симптоматика кишечной палочки (эшерихиоз, вызванный эшерихия коли 1 класса, также известный как токсическая диспепсия) чаще всего наблюдается у детей младшего возраста. Основные клинические проявления связаны с нарушением работы желудочно-кишечного тракта, что при легком течении проявляется в виде кашицеобразного или полужидкого стула, иногда с наличием слизи. При выраженных бродильных процессах в кишечнике стул может приобретать зеленоватый оттенок. В случае тяжелого течения стул становится обильным и водянистым, при этом кровь в кале фиксируется лишь у 2% пациентов. Рвота наблюдается у 50-60% больных с легкой формой и постоянно присутствует при токсическом или субтоксическом течении эшерихиоза. Если рвота возникает на 4-7 день болезни, особенно при тяжелом течении, это может указывать на токсическое поражение кишечника и центральной нервной системы.
Большинство пациентов с эшерихиозом испытывают лихорадку, которая может проявляться с первого дня заболевания у одних и позже у других. Обычно температура в начале болезни субфебрильная и нормализуется через несколько дней при легком течении. При тяжелом течении наблюдается новый подъем температуры до фебрильных значений на 4-7 день, что сопровождается усилением рвоты и диареи, нарастающей интоксикацией и ухудшением общего состояния. Для различных форм заболевания характерны определенные типы температурных кривых:
- Легкая форма эшерихиоза — субфебрильная температура в начале болезни, продолжающаяся 1-3 дня.
- Среднетяжелая форма — высокая температура в первые три дня, затем сменяющаяся длительным субфебрилитетом.
- Тяжелая форма — длительная высокая лихорадка ремиттирующего типа.
- Затяжные формы — периодически возникающая субфебрильная температура на протяжении длительного времени.
Повышение температуры на 4-7 день заболевания может свидетельствовать о развитии токсикоза и является тревожным симптомом. Клиника токсикоза включает в себя высокую температуру тела, одышку. Пациенты могут быть возбуждены или, наоборот, вялые, кожа становится бледной и цианотичной. Артериальное давление снижается, наблюдается тахикардия, сердечные тоны приглушены. Быстро развиваются олигурия, цилиндрурия, альбуминурия и эритроцитурия. В совокупности лихорадка, рвота, диарея и одышка часто приводят к эксикозу.
Клинические проявления варьируют в зависимости от тяжести заболевания:
- Легкая форма — проявляется вялостью, однократной рвотой в начале болезни, снижением аппетита, учащением стула до 3-6 раз в сутки. Стул жидкий, температура тела субфебрильная, сохраняется 3-4 дня. При пальпации живот безболезненный, небольшой метеоризм. Заболевание длится около недели.
- Среднетяжелая форма. Стул водянистый 9-12 раз в сутки, температура тела 38-39 °С. Рвота 2-3 раза в день. Симптомы кишечной палочки у детей более выражены: заболевание проявляется в виде энтеритов и энтероколитов различной степени тяжести, острое начало, кожа бледная и сухая, тургор тканей снижен, запавший большой родничок. Выражен метеоризм. Сердечные тоны глухие.
- Тяжелая форма — чаще встречается у новорожденных и недоношенных детей, а также у тех, кто на искусственном вскармливании. Характеризуется острым началом, слабостью, частой упорной рвотой до 5 раз в сутки, водянистой диареей до 20 раз в сутки, температура 38–39 °С, черты лица заострены, под глазами синие круги, запавший большой родничок. Потеря веса у детей до года может достигать 200-400 г в сутки. На фоне обезвоживания быстро развивается токсикоз и эксикоз, резко снижается масса тела, может возникнуть анурия и парез кишечника. У сильно ослабленных пациентов эшерихиоз часто протекает как генерализованная инфекция в септической форме.
При стертых формах общие симптомы практически отсутствуют, температура тела в большинстве случаев остается в пределах нормы. Основные признаки заболевания: нечастый кашицеобразный или жидкий стул, реже с примесью слизи. Симптомы дисфункции кишечника проходят быстро, даже без лечения. Затяжное течение (более 1,5 месяцев) чаще наблюдается у ослабленных детей в возрасте 1-6 месяцев. Может иметь рецидивирующее течение с частыми обострениями и повторным выделением того же серотипа escherichia coli в посеве на флору или непрерывное течение, при котором долгое время наблюдается неустойчивый стул с патологическими примесями. Носительство возможно у детей старше 6 месяцев, при этом в посеве на флору фиксируется 1-2 кратковременное выделение возбудителя.
Симптомы заражения кишечной палочкой (E. coli 2 класса) схожи с гастроинтестинальными формами сальмонеллеза. Заболевают как дети, так и взрослые. Инкубационный период составляет от 1 до 5 суток, заболевание начинается остро, с фебрильной температурой до 39 °С и частыми ознобами. Характерен жидкий стул без примесей крови или слизи до 5-10 раз в сутки, нечастая рвота и схваткообразные боли в животе. Течение заболевания доброкачественное, продолжительность составляет 3-5 дней. У взрослых симптомы кишечной палочки 2 класса аналогичны проявлениям сальмонеллеза.
Клиника эшерихиоза, вызываемого энтероинвазивными кишечными палочками (ЭИКП)
Заболевание проявляется в основном симптомами общей интоксикации и синдромом поражения кишечника, преимущественно толстой кишки. В медицинской практике чаще всего встречаются острые кишечные инфекции, вызванные эшерихией coli патотипа О124 и О151 (Крым). Наиболее подвержены заболеванию дети в возрасте от 3 до 7 лет, а также взрослые. Инкубационный период при эшерихиозе О124 может варьироваться от нескольких часов до 6 суток, в среднем составляет 2-5 дней. Заболевание начинается остро, с выраженными симптомами общей интоксикации, такими как слабость, озноб, головная боль, тошнота, снижение аппетита и боли в мышцах, в сочетании с признаками колита: болями в нижней части живота и частым жидким или кашицеобразным стулом (до 3-5 раз и более в сутки), иногда с примесью слизи или крови. Язык пациента покрыт налетом. В дистальном отделе толстой кишки наблюдаются уплотнение, спазмы и болезненность.
В тяжелых случаях консистенция кала меняется на жидкую, могут возникать тенезмы. Температура тела чаще всего остается нормальной или субфебрильной, однако в 20-30% случаев наблюдается высокая температура в диапазоне 38-39 °С. При проведении ректороманоскопии выявляется катаральный или катарально-эрозивный проктосигмоидит. Заболевание, как правило, имеет доброкачественное течение, чаще всего протекает в легкой форме, реже — в средней тяжести и очень редко — в тяжелой. Через 1-2 дня после нормализации температуры стул становится оформленным, симптомы интоксикации исчезают, однако спазмы и болезненность кишечника могут сохраняться до 10 дней.
Клиническая картина эшерихиоза, вызванного ЭИКП серовара О151, схожа с описанной выше. Однако для этого серовара характерен более короткий инкубационный период (1-2 дня). Заболевание начинается с диареи, тошноты, схваткообразных болей в животе и рвоты, которые чаще всего сопровождаются нормальной или реже субфебрильной температурой тела. В первый день болезни стул водянистый, в основном без примесей, может достигать 20 раз в сутки, что быстро приводит к обезвоживанию. Длительность диареи обычно составляет от 1 до 5 дней. При пальпации живот слабо болезненный, может наблюдаться урчание и спазмы сигмовидной кишки.
Клиника эшерихиоза, вызываемого энтеротоксигенными кишечными палочками (ЭТКП)
Основная форма заболевания, известная как «диарея путешественников», характеризуется холероподобным течением и поражением тонкого кишечника. Обычно она протекает без выраженного синдрома интоксикации. Инкубационный период составляет от 1 до 3 дней. Заболевание начинается остро, проявляясь чувством разбитости, тошнотой, общей слабостью и головной болью, к которым вскоре добавляются схваткообразные боли в области эпигастрия. Позже возникает рвота, сначала с остатками пищи, а затем — с жидкостью.
Тошнота усиливается, и через несколько часов начинается диарея: стул становится обильным, жидким и водянистым, без примесей слизи, с частотой 5-10 раз в сутки. Часто наблюдается дегидратация. Живот может быть вздут, слышно урчание, а изменения в толстой кишке отсутствуют. Лихорадка для данной формы заболевания не характерна. Болезнь может протекать как в легкой, так и в тяжелой форме. Основным показателем тяжести эшерехиоза является степень дегидратации (обезвоживания), что может привести к эксикозу. Возможен и молниеносный вариант развития заболевания с быстрым прогрессированием эксикоза. Продолжительность болезни составляет от 2 до 7 дней. В целом прогноз благоприятный, и выздоровление может наступить даже без специального лечения.
Клиника эшихириоза, вызываемого энтерогеморрагичными кишечными палочками (ЭГКП)
Заболевание характеризуется ярко выраженной симптоматикой общей интоксикации и поражением толстой кишки, в основном проксимального отдела. Основным возбудителем данного типа эшерихиозов является эшерихия серовара О157:Н7. Инкубационный период составляет от 2 до 4 дней, однако может варьироваться от 1 до 10 дней. Клинические проявления эшерихиозов этого типа включают:
- острый геморрагический колит (ГК), схожий с язвенным;
- диарею без наличия крови;
- бессимптомное носительство;
- тяжелые формы с развитием ГУС и неврологическими проявлениями;
- тромботическую тромбоцитопеническую пурпуру.
При типичном течении заболевания наблюдается резкое начало с дизентериеподобными симптомами: тошнота, рвота, интенсивные схваткообразные боли в животе, преимущественно в правой подвздошной области, жидкий стул, который может возникать от 3 до 10-15 раз в сутки без примеси крови. Температура тела в большинстве случаев субфебрильная, в легких случаях наблюдается небольшое повышение температуры. Потеря жидкости в легких случаях умеренная. Симптомы могут сохраняться несколько дней.
При неблагоприятном течении заболевания симптомы усиливаются, что проявляется увеличением болей в животе и появлением крови в стуле. Появление крови в испражнениях (независимо от ее объема) является клиническим признаком развития геморрагического колита (ГК), который наблюдается у 33-90% пациентов. У 30% больных с ГК также отмечаются тошнота и рвота. При неосложненном течении заболевание у взрослых продолжается 7-8 дней, а у детей — до 14 дней. В тяжелых случаях почти у 20% пациентов к острому ГК присоединяется уремический синдром, что приводит к острой почечной недостаточности, часто с судорожным синдромом. У 20% пациентов развивается тромботическая пурпура, проявляющаяся геморрагиями по всему пищеварительному тракту, симптомами гломерулонефрита и, в конечном итоге, развитием острой почечной недостаточности (ОПН).
У около 10% пациентов с ГК может развиться ГУС (синдром Гассера), для которого характерна триада симптомов: гемолитическая анемия, тромбоцитопения и нефропатия, вплоть до ОПН. Выделяют неполные формы ГУС, которые могут развиваться после перенесенного ГК и проявляются транзиторной гематурией, протеинурией, но без тромбоцитопении, гемолитической анемии и ОПН. В некоторых случаях могут наблюдаться тромбоцитопения и гемолитическая анемия, однако признак ОПН отсутствует.
Для полного типа ГУС характерно острое начало, возникающее через 2-15 дней после прекращения диареи. Симптоматика включает рвоту, значительное снижение диуреза, повышение уровня креатинина и мочевины, гемолитическую анемию, микрогематурию, тромбоцитопению и артериальную гипертензию. К вышеупомянутой триаде у многих пациентов присоединяются нарушения церебрально-неврологического характера ( тремор, раздражительность, эпилептические приступы, вплоть до комы). Летальность среди пациентов с развившимся после ГК ГУС составляет от 3 до 5%.
Клиника эшерехиоза, вызываемого энтероадгезивными кишечными палочками (ЭАКП)
Заболевание недостаточно исследовано и чаще всего наблюдается у пациентов с ослабленным иммунитетом. Оно в основном проявляется в виде внекишечных форм, связанных с поражением мочевыводящих и желчевыводящих путей, таких как цистит, простатит, пиелонефрит, холецистит и холангит. Это подтверждается наличием Escherichia coli в мазках из урогенитального канала как у мужчин, так и у женщин. Реже встречаются септические формы, такие как менингит и коли-сепсис.
Часто в мазках на флору у мужчин обнаруживается кишечная палочка в моче. Основные причины ее появления включают несоблюдение правил интимной гигиены (перенос из кишечника), анальный секс, а в редких случаях — купание в открытых водоемах. Что касается присутствия кишечной палочки в сперме, то в норме ее не должно быть, однако при прохождении через инфицированную область уретры она может оказаться в эякуляте.
Крайне важно, чтобы титр кишечной палочки не превышал 106 КОЕ/мл. В противном случае следует проявить осторожность, так как инфекция в мочевыводящих путях может привести к различным полиморфным поражениям, от бессимптомной бактериурии до выраженных форм, таких как цистит и острый пиелонефрит.
У женщин кишечная палочка часто обнаруживается во влагалище, хотя в норме ее присутствие недопустимо. Основные причины попадания кишечной палочки во влагалище включают:
- Неправильное соблюдение личной гигиены, например, подмывание в неправильном направлении (сзади наперед);
- Анальный секс без предохранения, при котором флора кишечника может попасть во влагалище;
- Половой акт с мужчиной, страдающим простатитом;
- Использование перфорированных интимных средств, которые могут нарушать pH влагалища и состав микрофлоры;
- Ношение обтягивающего нижнего белья или стрингов, что способствует переносу E. coli из анального отверстия во влагалище.
Тем не менее, стоит отметить, что наличие E. coli в мазках у женщин может не свидетельствовать о проблемах в гинекологии и быть частью условно-патогенной флоры влагалища, если ее количество не превышает 10^2 КОЕ/мл, а признаки воспаления (лейкоциты) и жалобы отсутствуют.
Анализы и диагностика
Постановка диагноза эшерихиоз (инфекция, вызванная кишечной палочкой) основывается на данных эпидемиологических, клинических, лабораторных и частично инструментальных исследований. Диагностика эшерихиоза, особенно в случаях спорадической заболеваемости, может быть затруднена из-за разнообразия симптомов. В связи с этим для различения кишечных эшерихиозов по клинической симптоматике представлена сводная таблица, отражающая особенности проявлений различных патогенетических групп кишечных палочек.
| Категория E. coli | ЭТКП | ЭИКП | ЭПКП | ЭГКП |
| Заражающая доза, микробные клетки | 10^8-10^10 | 5 x 10^5 | 10^5-10^10 | Нет данных |
| Инкубационный период, ч | 16-72 | 6-48 | 6-24 | 72-120 |
| Локализация патологического процесса | Тонкая кишка | Нижний отдел подвздошной и толстая кишка | Тонкая кишка | Слепая, восходящая и поперечно-ободочная толстая кишка |
| Клинические синдромы | ||||
| Преобладающий синдром | Холероподобный: кишечные спазмы, тошнота, рвота, водянистая диарея | Дизентериеподобный: начальная непродолжительная водянистая диарея сменяется колитическим синдромом | Продолжительная водянистая диарея, рвота | Колитический: острое начало с кишечными спазмами, кратковременная водянистая диарея, быстро сменяющаяся прогрессирующей гемодиареей |
| Явления дегидратации | Явления эксикоза | Выраженный эксикоз | ||
| Температура тела | Обычно нормальная, иногда субфебрильная | Повышение, токсикоз | Субфебрильная, чаще нормальная | Нормальная или незначительно повышена |
| Изменения в испражнениях | Нет примесей или небольшое количество слизи | Небольшие примеси крови, слизь и полиморфноядерные лейкоциты | Примесь слизи | Обилие крови при отсутствии лейкоцитов |
| Длительность заболевания | Острый период длится 3-4 дня | 1-2 недели | Возможно тяжелое пролонгированное (более 2 недель) течение | В пределах 8 дней |
При клиническом обследовании важно обратить внимание на наличие и степень выраженности интоксикации, обезвоживания, а также выявление ведущего синдрома поражения желудочно-кишечного тракта:
- Синдром острого гастрита — проявляется чувством тяжести и периодическими болями в области эпигастрия, тошнотой, рвотой, болезненностью при пальпации.
- Синдром острого энтерита — обильный водянистый стул, часто пенистый с примесью непереваренной пищи, зеленовато-желтоватого цвета, урчание и периодические боли без четкой локализации. Обезвоживание может быть различной степени.
- Синдром острого колита — характеризуется периодическими схваткообразными болями в нижней части живота, часто с ложными позывами на дефекацию. При тяжелом течении стул скудный, частый, не каловый, состоящий из слизи с примесью крови. При пальпации — болезненность и уплотнение некоторых участков толстой кишки, после дефекации ощущение неполного опорожнения кишечника.
Часто наблюдается колиэнтерит, когда в воспалительный процесс вовлекаются как толстый, так и тонкий кишечник.
Окончательный диагноз эшерихиоза устанавливается только после выделения возбудителя и серологического подтверждения. Объектами бактериологического исследования могут быть рвотные массы, испражнения, промывные воды желудка и кровь в случае генерализованных форм.
Для диагностики могут применяться серологические методы (РНГА, реакция иммунофлуоресценции, реакция нейтрализации и другие), хотя их информативность значительно ниже. Также возможны ложноположительные результаты, так как существует антигенное сходство эшерихий с другими энтеробактериями. Перспективным методом диагностики является ПЦР (полимеразная цепная реакция). Инструментальные методы (колоноскопия/ректороманоскопия) имеют низкую информативность при эшерихиозах.
Дифференциальную диагностику необходимо проводить с сальмонеллезом, дизентерией, кампилобактериозом и пищевыми токсикоинфекциями. При наличии быстро развивающегося выраженного обезвоживания следует учитывать энтеровирусную и ротавирусную инфекцию, а также холеру.
Лечение кишечной палочки
Лечение эшерихиозов является многоступенчатым процессом. Оно включает в себя специальное диетическое питание, патогенетическую и симптоматическую терапию. Основная цель лечебного процесса заключается в уничтожении возбудителя и его токсинов, а также в восстановлении обмена веществ и нормализации работы различных органов. Обычно пациенты с легкими формами заболевания могут проходить лечение амбулаторно, без необходимости госпитализации. Однако при среднетяжелых и тяжелых формах заболевания требуется госпитализация в инфекционные стационары.
При легком течении эшерихиоза у взрослых, особенно при дегидратации первой степени, рекомендуется проводить пероральную регидратационную терапию с использованием таких препаратов, как Глюкосолан, Регидрон и Цитроглюкосолан. Объем вводимой жидкости должен превышать потери жидкости из организма с испражнениями примерно в 1,5 раза.
В случае легкого течения болезни целесообразно назначать кишечные антисептики, такие как Неоинтестопан, Интетрикс и Энтерол, в течение 5-7 дней. Лечение escherichia coli также включает применение ферментативных препаратов, которые помогают восполнить недостаток панкреатических ферментов, нормализовать катаболизм и улучшить усвоение питательных веществ, а также снизить стеаторею и симптомы, связанные с мальдигестией. Для этого могут быть назначены препараты, такие как Мезим форте, Креон, Панзинорм форте и Фестал. Эффективным дополнением к терапии являются энтеросорбенты, такие как Полифепан, Полисорб, Энтеросгель и Энтеродез, которые рекомендуется принимать в течение 1-3 дней.
Пациенты с более тяжелыми формами заболевания, находящиеся в стационаре, должны соблюдать строгий постельный режим в первые 2-3 дня и получать этиотропную терапию. При среднетяжелых формах чаще всего назначаются Ко-тримоксазол ( Септрин, Бактрим, Бисептол) и антибиотики группы фторхинолонов, которые действуют путем ингибирования топоизомеразы и ДНК-гиразы.
Рекомендуется использование препаратов Ципролет, Ципробай и Ципросол, которые обладают широким антимикробным спектром, выраженным бактерицидным действием и хорошей фармакокинетикой (высокая биодоступность, быстрое достижение максимальной концентрации в крови), что способствует уничтожению возбудителя. Также возможно назначение перорально на 5-7 дней Пефлоксацина ( Абактал) и Офлоксацина ( Таривид).
При тяжелых формах заболевания фторхинолоны применяются в сочетании с цефалоспоринами II поколения ( Цефаклор, Цефуроксим, Цефтриаксон) и III поколения ( Цефтазидим, Цефоперазон). В случае выраженной дегидратации (2-3 степени) показана интенсивная регидратационная терапия кристаллоидными растворами, такими как Ацесоль, Квартасоль, Хлосоль и Лактосоль. Объем жидкости, вводимой внутривенно, рассчитывается с учетом степени обезвоживания и веса пациента. Первый этап терапии направлен на устранение уже имеющегося обезвоживания, а второй — на коррекцию текущих потерь жидкости. При выраженной интоксикации могут быть назначены коллоидные растворы в объеме до 800 мл в сутки ( Реополиглюкин, Гемодез).
Особое внимание следует уделить лечению пациентов с эшерихиозом 0157 из-за высокого риска осложнений. После антибактериальной терапии, если диарея продолжается, назначаются эубиотики, которые помогают восстановить баланс микрофлоры и корректировать дисбактериоз. Обычно такие препараты назначаются на 7-10 дней, например, Бифиформ, Пробифор, Бифистим, Аципол и Бифидумбактерин форте. На данный момент не разработана сыворотка против эшерихиоза у людей. Существующие поливалентные сыворотки предназначены для диагностики и серологической идентификации эшерихий.
Выписка пациентов с диагнозом «эширихиоз» осуществляется только после полного выздоровления (отсутствия клинических симптомов) и получения двух отрицательных результатов бактериологического исследования кала, с последующим наблюдением в диспансере в течение двух месяцев.
Лечение внекишечных эширихиозов
Внекишечные проявления эшерихиоза могут проявляться в виде различных нозологических форм, таких как дисбактериоз, пиелонефрит, цистит, холецистит, сепсис, менингит и заболевания в области гинекологии. Каждое из этих состояний требует индивидуального подхода к лечению.
Лечение при кишечной палочке в моче
Выявление эшерихии коли в моче у мужчин и женщин чаще всего указывает на наличие хронического воспалительного процесса в мочевыводящих путях, который может протекать бессимптомно или проявляться в виде конкретных заболеваний, таких как цистит, простатит или вагинит. Каждое из этих состояний требует индивидуального подхода к лечению, включая назначение антибиотиков и проведение соответствующих медицинских процедур.
Лечение кишечной палочки в гинекологии
Обнаружение кишечной палочки во влагалище является тревожным сигналом, который может нарушить естественный баланс микрофлоры. В условиях ослабленного иммунитета это может привести к воспалительным процессам в мочеполовых органах женщины. Если в мазке у женщин выявляется кишечная палочка, особенно на фоне увеличенного количества лейкоцитов, необходимо провести дополнительные исследования и назначить антибактериальную терапию с учетом чувствительности данного микроорганизма.
Особое внимание следует уделить лечению кишечной палочки в мазках, полученных из различных сред вне кишечника у детей младше года, особенно у недоношенных и ослабленных. Это связано с высоким риском развития сепсиса, который может проявляться воспалительными процессами в различных органах, такими как инфекция мочевыводящих путей, пневмония, артрит, менингит и эндокардит, а также инфекционно-токсическим шоком, который имеет высокие показатели смертности.
Лекарства
РегидронАцесольЭнтеролКо-тримоксазолЦипробайОфлоксацинПолисорбЭнтеросгельБифидумбактерин ФортеБифиформПробифорКреон
- Растворы для регидратации: Глюкосалан, Регидрон, Цитроглюкосалан, Квартасоль, Хлосоль, Лактосоль.
- Антисептики для кишечника: Неоинтестопан, Интетрикс, Энтерол.
- Антибиотики: Ципролет, Офлоксацин, Ципробай, Ципросол, Цефаклор, Цефуроксим, Цефтазидим, Цефтриаксон, Цефоперазон.
- Энтеросорбенты: Полифепан, Полисорб, Энтеросгель, Энтеродез.
- Пробиотики: Бифиформ, Пробифор, Бифистим, Аципол, Бифидумбактерин форте.
- Ферментные препараты: Мезим форте, Панзинорм форте, Креон, Фестал.
Процедуры и операции
Лечение кишечных эшерихиозов не предусмотрено.
Профилактика
Специфическая профилактика кишечной палочки не разработана. Основные меры по предотвращению эшерихиозов сосредоточены на ограничении путей передачи возбудителя и включают в себя:
- Соблюдение санитарно-гигиенических стандартов на объектах общественного водоснабжения и питания, а также в местах для купания.
- Профилактику контактно-бытового заражения в организованных коллективах, таких как детские учреждения и больницы, путем дезинфекции рук, предметов обихода, посуды, пастеризации молока и молочных смесей, а также использованием одноразовых пеленок.
- В случае выявления очага эшерехиоза необходимо проводить специальные противоэпидемические мероприятия. Поскольку основным фактором передачи эшерихиозов являются пищевые продукты, важно соблюдать меры предосторожности при их приготовлении.
- Поддерживайте чистоту рук (мойте их с мылом перед готовкой и после посещения туалета) и кухонного инвентаря (очищайте и дезинфицируйте кухонные принадлежности и поверхности), а также боритесь с насекомыми на кухне.
- Отделяйте сырые и готовые продукты (мясо, птицу, морепродукты), используйте отдельные разделочные доски, кухонные инструменты и ножи для обработки сырых продуктов, храните их в отдельных закрытых контейнерах.
- Соблюдайте температурный режим при приготовлении пищи, особенно для мяса, молока, куриных яиц и морепродуктов (обжаривайте или варите продукты в течение достаточного времени). Не употребляйте их в полусыром виде.
- Храните все скоропортящиеся и приготовленные продукты при безопасной температуре (ниже 5° С), не оставляйте готовую пищу вне холодильника более чем на 2 часа, даже если она находится в холодильнике.
- Используйте качественную (фильтрованную) воду и безопасные сырые продукты — тщательно мойте сырые фрукты и овощи, избегайте употребления продуктов с истекшим сроком годности.
Кишечная палочка у детей, особенности течения
Как уже упоминалось, эшерихиоз у детей протекает значительно тяжелее, чем у взрослых. В отличие от старших детей, новорожденные и малыши до одного года, особенно недоношенные и ослабленные, чаще всего сталкиваются с заболеванием в среднетяжелой или даже тяжелой форме. У грудничков кишечная палочка, помимо классических симптомов, вызывает быстрое обезвоживание, выраженную интоксикацию и нарушения терморегуляции.
У новорожденных, особенно у недоношенных и ослабленных, инкубационный период сокращается до 1-2 дней. Заболевание обычно начинается остро с проявлений энтерита — водянистые испражнения до 10 раз в сутки, реже кашицеобразные желтого цвета с добавлением прозрачной слизи. Как правило, сразу возникают рвота или постоянные срыгивания. Клинические симптомы постепенно усиливаются, общее состояние ребенка ухудшается: снижается аппетит, появляется вялость, адинамия, субфебрильная или фебрильная температура. У большинства детей наблюдается токсикоз с соледефицитным эксикозом.
У таких детей может быть субнормальная температура тела, холодные конечности, глухие сердечные тоны и тахикардия, токсическое дыхание, реже — судороги и помрачение сознания. При осмотре отмечаются бледность и сухость кожи, акроцианоз, западание большого родничка. В тяжелых случаях возможно развитие ДВС-синдрома, острого почечного недостатка и инфекционно-токсического шока.
Продолжительность заболевания может варьироваться от нескольких дней до 20 дней. У ослабленных детей с иммунной недостаточностью, гипотрофией или дисбактериозом кишечника заболевание может затягиваться (более 1 месяца). Часто при обследовании у таких детей выявляется гемолизирующая E. coli или лактозонегативная кишечная палочка в высокой концентрации.
У новорожденных и детей первых месяцев жизни возможно общее распространение инфекции из первичного очага (кишечника) в другие органы, что может привести к сепсису с воспалительными очагами (пневмония, менингит, энцефалит).
При обнаружении escherichia coli в моче у ребенка существует высокий риск инфекций мочевыводящих путей. Если при бакпосеве у ребенка до года выявляются гемолитические E. coli в кале, это должно вызывать настороженность, так как такие эшерихии могут повреждать эндотелий кровеносных сосудов и вызывать гемолиз эритроцитов, что приводит к некрозу стенки кишечника и кровотечениям. Кроме того, именно гемолитическая E. coli в кале считается основной причиной развития ГУС.
Энтеропатогенный эшерихиоз часто встречается у недоношенных новорожденных и в условиях стационаров (особенно в отделениях для выхаживания недоношенных детей) как внутрибольничная инфекция (госпитальные антибиотикоустойчивые штаммы). Его отличает склонность к быстрой генерализации процесса с частым развитием сепсиса и гнойного менингита при невыраженном диарейном синдроме. Эшерихиозные менингиты и энцефалиты имеют тяжелое клиническое течение, характеризуются высокой летальностью, а при выздоровлении существует риск развития гидроцефалии и других осложнений со стороны центральной нервной системы.
Кишечная палочка при беременности
Обнаружение escherichia coli в моче у беременной женщины указывает на наличие урогенитального дисбактериоза, который проявляется снижением уровня лактобактерий и увеличением количества условно-патогенной флоры, включая кишечную палочку. При наличии симптомов важно провести полное обследование урогенитального тракта. Хотя escherichia coli не входит в группу TORCH-инфекций, ее присутствие в моче во время беременности, на фоне изменений гормонального фона, застоя мочи из-за давления плода на соседние органы и снижения иммунной защиты, может привести к воспалительным процессам в органах урогенитального тракта. Это, в свою очередь, может осложнить беременность и стать причиной таких проблем, как маловодие, прерывание беременности, преждевременное отхождение околоплодных вод, инфицирование плодных оболочек и нарушения внутриутробного развития плода.
Наилучший способ устранения урогенитального дисбактериоза — это подготовительный период перед беременностью, так как слизистая влагалища становится более рыхлой и подверженной воздействию условно-патогенных микроорганизмов, способствующих воспалению, что негативно сказывается на процессе вынашивания. Если подготовка не была проведена заранее, коррекцию микрофлоры следует осуществлять под контролем гинеколога, избегая самостоятельного применения антибиотиков, которые могут быть небезопасны для плода.
Диета
Диета Стол №4
- Результативность: оздоровительный эффект проявляется в течение 7-10 дней
- Продолжительность: 21 день
- Цена продуктов: 1120-1150 рублей в неделю
Диетический Стол №2
- Результативность: терапевтический эффект наблюдается уже через 3 недели
- Продолжительность: от 1 месяца и дольше
- Цена товаров: 1550-1600 рублей в неделю
Диета 13 стол
- Эффективность: лечебный эффект проявляется через 4 дня
- Сроки: не более 2 недель
- Стоимость продуктов: 1500-1600 рублей в неделю
В острый период эшерехиоза (во время диареи) рекомендуется соблюдать лечебную диету, которая щадит желудочно-кишечный тракт ( Стол №4). Когда стул начинает нормализоваться, переходят на диетический Стол №2, а в период выздоровления — на лечебный Стол №13.
Детям с легкой формой заболевания следует пропустить одно-два кормления или уменьшить объем каждого из них на 1/3 — 1/2 в течение первых двух суток. Постепенно объем пищи увеличивается, и к четвертому дню он достигает возрастной нормы. Важно также следить за тем, чтобы ребенок получал достаточное количество жидкости в течение разгрузочного периода и далее.
Для детей до года с тяжелым течением болезни рекомендуется 8-12 часов водно-чайной паузы, при этом необходимо обеспечить поступление достаточного количества жидкости (чай, раствор Рингера с 5% глюкозой, отвар изюма или моркови). В случае необходимости можно вводить регидратационные растворы внутривенно. После паузы детям грудного возраста следует давать грудное молоко или специализированные смеси.
Объем пищи должен постепенно увеличиваться, а частота кормлений — уменьшаться, чтобы к 7-8 дню достичь объема питания, соответствующего возрасту. Детям в возрасте 1-3 года после водно-чайной паузы можно давать кефир с интервалом в 3 часа по 50-150 мл. В последующие дни в рацион вводятся протертые каши, молотое мясо, вареные овощи, кисели и сухари с постепенным переходом на обычное питание.
С первых дней болезни рекомендуется включать в рацион детей лечебно-профилактические продукты, содержащие лакто/ бифидобактерии. При выраженных бродильных процессах в кишечнике следует использовать безлактозные или низколактозные продукты, что способствует быстрому устранению нарушений функций ЖКТ, нормализации биоценоза кишечника и улучшению показателей клеточного звена иммунитета.
Последствия и осложнения
При тяжелом течении эшерихиозов, особенно у новорожденных и ослабленных детей до года, существует высокий риск возникновения осложнений, таких как:
- инфекционно-токсический шок;
- гемолитико-уремический синдром с развитием острой почечной недостаточности;
- инфекции мочеполовой системы ( пиелоцистит, нефрит, вагинит);
- сепсис;
- менингит или менингоэнцефалит;
- пневмония.
Прогноз
Прогноз является положительным при условии своевременного и правильного лечения. Смертельные случаи чаще всего фиксируются при синдроме Гассера, когда у детей младше 5 лет развивается острая почечная недостаточность.
Список источников
- Бехтерева М.К., Иванова В.В., Семенова С.Г., Раздьяконова И.В. Основы антимикробной терапии острых кишечных инфекций у детей. Педиатрия. (Прил.) 2015; 02: 51-56 с.
- Горелов А.В., Милютина Л.Н., Усенко Д.В. Рекомендации по диагностике и лечению острых кишечных инфекций у детей. Руководство для врачей. М., 2006.
- Аликеева Г. К., Ющук Н. Д., Кожевникова Г. М., Эшерихиозы. Лечащий врач: 2007, 11-16 с.
- Покровский В. И. и др. Инфекционные болезни и эпидемиология. М.: ГЭОТАР, 2003. С. 256–264.
- Ющук Н. Д., Венгеров Ю. Я. Лекции по инфекционным заболеваниям. М.: ВУНМЦ, 1999. Т. 1. С. 143–150.
Исследования и новые методы диагностики кишечной палочки
Кишечная палочка, или Escherichia coli, представляет собой род бактерий, который включает как безвредные, так и патогенные штаммы. В последние годы исследования в области диагностики кишечной палочки значительно продвинулись вперед, что позволяет более эффективно выявлять и контролировать инфекции, вызванные этими микроорганизмами.
Одним из основных направлений исследований является разработка новых молекулярных методов диагностики. ППЦР (полимеразная цепная реакция) и его модификации, такие как qPCR (количественная ПЦР), позволяют быстро и точно идентифицировать патогенные штаммы E. coli. Эти методы основываются на амплификации специфических участков ДНК, что делает их высокочувствительными и специфичными.
Кроме того, в последние годы активно исследуются методы, основанные на использовании нуклеиновых кислот, такие как LAMP (изотермическая амплификация). Этот метод позволяет проводить диагностику без необходимости в сложном оборудовании, что делает его особенно полезным в условиях ограниченных ресурсов.
Также стоит отметить, что современные технологии секвенирования ДНК, такие как секвенирование следующего поколения (NGS), открывают новые горизонты для изучения генетического разнообразия штаммов E. coli. Эти технологии позволяют не только идентифицировать патогенные штаммы, но и исследовать их генетическую структуру, что может помочь в понимании механизмов патогенности и устойчивости к антибиотикам.
Важным аспектом диагностики является также использование серологических методов, которые позволяют выявлять антитела к специфическим антигенам E. coli. Эти методы могут быть полезны для диагностики инфекций, вызванных определенными штаммами, такими как E. coli O157:H7, известный своей патогенностью.
Совсем недавно в исследованиях начали применять методы, основанные на использовании биосенсоров. Эти устройства могут быстро и точно определять наличие кишечной палочки в образцах, таких как вода или пищевые продукты, что делает их полезными для мониторинга безопасности пищевых продуктов и контроля качества воды.
Таким образом, современные исследования и новые методы диагностики кишечной палочки открывают новые возможности для своевременного выявления и контроля инфекций, что в свою очередь способствует улучшению общественного здоровья и безопасности продуктов питания.
Вопрос-ответ
Чем опасна кишечная палочка для человека?
Различные виды кишечной палочки, попав в организм человека, способны провоцировать патологии. Чаще всего они вызывают кишечную инфекцию, сопровождающуюся сильной диареей. При несвоевременном лечении такой патологии человек может получить гемолитико-уремический синдром, который ведёт к заболеванию почек.
Как и чем убить кишечную палочку?
Основа лечения кишечных инфекций в легкой форме – регидратация (восполнение потерянной жидкости тела больного путем приема солевых растворов внутрь) и дезинтоксикационная терапия. Для выведения токсических продуктов возбудителя используются сорбенты, эубиотики, ферменты и вяжущие средства.
Откуда можно заразиться кишечной палочкой?
Помытые инфицированной водой овощи, недожаренные рыба и мясо, невымытые после туалета руки – все это может привести к заражению. Болезнетворные штаммы эшерихии передаются фекально-оральным путем. Это означает, что в наш организм через рот попадают крошечные частицы фекалий с E. Coli.
Советы
СОВЕТ №1
Следите за гигиеной: Регулярно мойте руки с мылом, особенно перед едой и после посещения туалета. Это поможет предотвратить попадание кишечной палочки и других патогенов в ваш организм.
СОВЕТ №2
Правильно готовьте пищу: Убедитесь, что мясо, особенно курица и говядина, готовится до безопасной температуры. Используйте термометр для мяса, чтобы избежать недоготовки, которая может привести к заражению кишечной палочкой.
СОВЕТ №3
Избегайте употребления сырой или недостаточно обработанной пищи: Старайтесь не есть сырые яйца, молочные продукты и мясо, если вы не уверены в их качестве и безопасности. Это особенно важно для уязвимых групп, таких как дети и пожилые люди.
СОВЕТ №4
Проверяйте сроки годности продуктов: Убедитесь, что вы употребляете только свежие и качественные продукты. Не забывайте проверять упаковку на наличие повреждений и следите за сроками хранения.